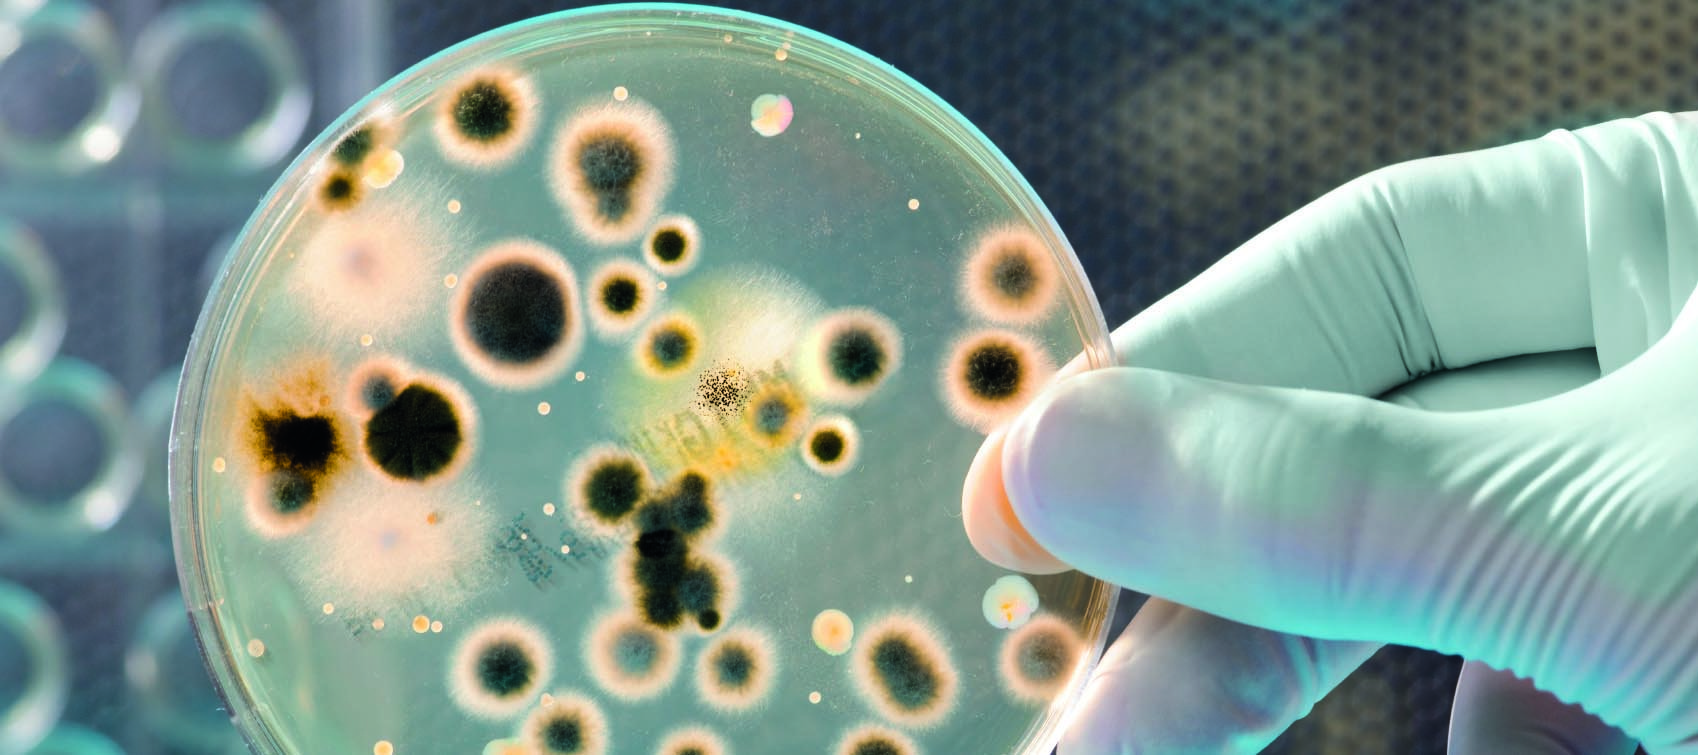

Department of Health representatives “introduced discussion” on declaring the public health emergency on carbapenemase-producing Enterobacteriaceae (CPE) to be over at a national public health emergency team (NPHET) meeting in September, the Medical Independent (MI) understands.
A reference to the Department initiating this discussion is included in minutes of the November meeting of the CPE expert group at the Health Protection Surveillance Centre (HPSC).
Chair of the expert group, Prof Hilary Humphreys, noted there had been “a lot of changes in the governance structure” and proposed to write to the Chief Medical Officer Dr Tony Holohan, outlined the minutes.
According to minutes of the September meeting of the NPHET, there was consideration of the conditions whereby the “NPHET process” might be concluded, while acknowledging the need for “continued emphasis” on CPE at policy and operational levels.
As recently reported in MI, the HSE is still awaiting further resources for screening, which are considered urgent in ongoing efforts to stop CPE becoming endemic in Irish healthcare.
A HSE spokesperson said discussions on additional funding were ongoing.
According to the spokesperson, the HSE was satisfied to continue working closely with the Department on managing CPE either through the NPHET or any alternative mechanism that the Department may propose “if the public health emergency is declared to be over”.
Speaking to MI in late February, the head of the HSE’s antimicrobial resistance and infection control team Prof Martin Cormican said progress had been made, but he was unsure if the battle was being won.
“We have not interrupted transmission in many hospitals, but we have in some… Right now the situation is there is continuing transmission in the acute hospital sector – it is being contained to some degree, but not reversed and not contained fully.”
He said efforts were “buying us time to get on top of this and I think there is still a chance… but I think we will need to up the game quite a bit in 2019 and 2020 if we are actually going to try and put this back in the box”.
Prof Cormican also referred to infection prevention and control and antimicrobial stewardship capacity in the community as “very weak”.
The public health emergency was declared by Minister for Health Simon Harris in October 2017.

Leave a Reply
You must be logged in to post a comment.